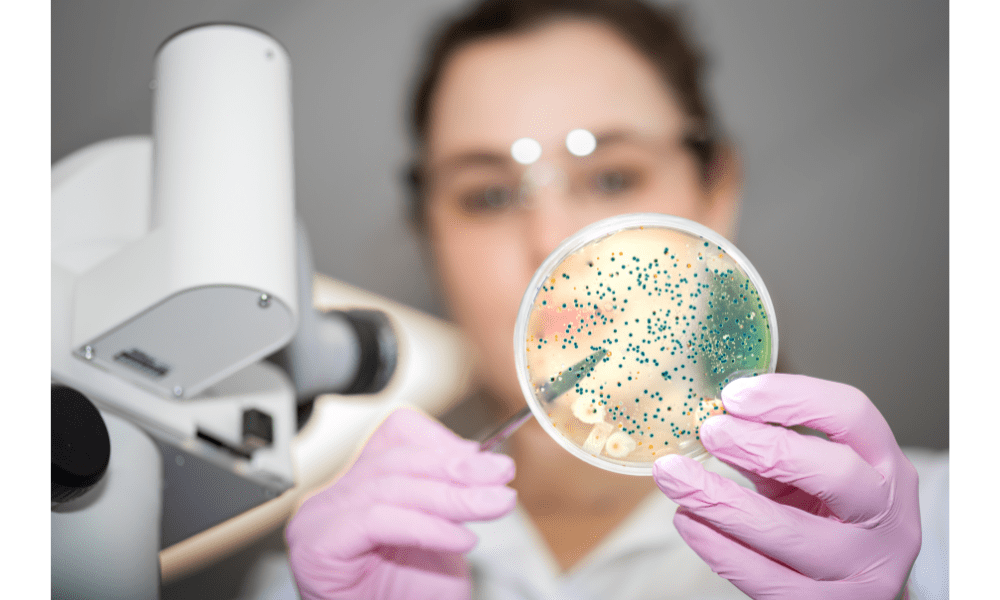

Have you recently been diagnosed with an enlarged prostate? If so, you’re certainly not alone.
An enlarged prostate also known as benign prostatic hyperplasia (BPH) is the most common problem for US men over the age of 50. By the age of 60, it’s estimated that around 50% of all men will have the condition and this figure rises to 90% for men aged 85. While BPH is by its very name benign and never cancerous, the connection between gut bacteria, BPH and prostate cancer makes for interesting reading.
Introduction
Benign Prostatic Hyperplasia (BPH), a condition characterized by the enlargement of the prostate gland, is a prevalent issue among aging men. While age and genetics are established risk factors, emerging research is uncovering an intriguing link between BPH and prostate cancer, with the gut microbiome emerging as a critical player in this complex landscape. This article delves into the fascinating connection between gut bacteria, BPH, and prostate cancer, shedding light on how the composition of the gut microbiota may influence these conditions. So, let’s jump in and get started.
The Gut Microbiome: An Influential Ecosystem
The gut microbiome contains trillions of microorganisms with a diverse range of species, including fungi, parasites, viruses and bacteria. These microbes co-exist peacefully in healthy people with the largest numbers inhabiting the small and large intestines as well as throughout the body. This ecosystem plays a pivotal role in our health and wellness, influencing digestion, metabolism, immune function, and even mental well-being. Recent scientific advances have linked the gut microbiome to various diseases, including obesity, diabetes, autoimmune disorders, and cancer.
Benign Prostatic Hyperplasia (BPH): An Age-Related Challenge
BPH, often considered a natural consequence of aging, involves the non-cancerous enlargement of the prostate gland. It can lead to urinary symptoms such as frequent urination, urgency, and difficulty emptying the bladder. While not directly cancerous, BPH shares some risk factors and biological features with prostate cancer, making it an interesting subject of study in the context of the gut microbiome.
The Gut Microbiome-BPH Connection
- Inflammation and Immune Response: The gut microbiome significantly influences the immune system, with the majority of immune cells residing in the gut. Dysbiosis, or an imbalance in gut bacteria, can lead to chronic inflammation throughout the body, including the prostate. Chronic inflammation has been linked to the development and progression of BPH.
- Hormone Regulation: Certain gut bacteria are involved in metabolizing hormones, including dihydrotestosterone (DHT), a hormone implicated in prostate enlargement. An altered balance of gut bacteria may disrupt hormone metabolism and contribute to the growth of the prostate gland in BPH.
- Gut Microbes and Toxin Production: Specific gut bacteria can produce toxins that have been associated with prostate enlargement. Understanding how these toxins affect the prostate and contribute to BPH is an area of ongoing research.
The Gut Microbiome-Prostate Cancer Connection
- Shared Risk Factors: BPH and prostate cancer share common risk factors, such as age and genetics. Therefore, understanding the gut microbiome’s role in one condition may shed light on its potential influence on the other.
- Immunomodulation: An imbalanced gut microbiota can impact the immune system’s responses, potentially affecting the way immune cells recognize and respond to changes in the prostate, both in the context of BPH and prostate cancer.
The low-down
The intricate relationship between the gut microbiome, BPH, and prostate cancer is a promising area of research that may provide valuable insights into these conditions. While the precise mechanisms connecting gut bacteria to BPH and prostate cancer remain subjects of ongoing investigation, maintaining a healthy gut microbiome is increasingly recognized as essential for overall health and may play a critical role in reducing the risk of both BPH and prostate cancer.
How To Improve Your Gut Microbiome – 3 Top Tips
Adding certain foods to your diet and eliminating others can help balance your gut microbiome, reducing the risk of developing chronic disease and promoting overall health.
While research is continuing to emerge, it’s evident that certain foods and dietary practices make the microbiome more resilient while others cause inflammation. Below are 3 simple practices you can implement to improve your gut microbiome, starting with immediate effect.
- Add prebiotic-rich foods to every meal – When we consume prebiotic foods, they are selectively consumed by healthy gut-associated microbes. By supporting the healthy microbes in the body it helps them thrive and multiply, thus avoiding overcrowding by more disease-related microbes. Prebiotic-rich foods include artichokes, onions, garlic, legumes, beans, apples, bananas, seeds such as flax and chia and even green or black tea.
- Embrace fermented foods – These foods have been transformed with the assistance of yeast or bacteria and act as natural probiotic supplements when we eat them. Foods such as miso, yoghurt, kombucha, sauerkraut and kimchi increase microbe diversity in the gut and lower inflammation triggers.
- Include plants – Another way to increase the diversity of microbes in your gut is to consume a variety of whole-plant foods. Try seasonal foods available from your local farmer’s market that you may not have had before or add fresh herbs to a salad.
Making a few healthy changes to your diet may help you manage your BPH and lower the risk of heart disease, erectile dysfunction and diabetes.
When to seek treatment for BPH
You should seek treatment if you are experiencing BPH symptoms that affect your quality of life. These include losing sleep because you need to urinate during the night or not being able to urinate.
At the Midwest Institute for Non-surgical Therapy, we perform prostate artery embolization on an outpatient basis. If you have an enlarged prostate and want to know more about your condition and how we can help you, contact MINT today and schedule a consultation at one of our 4 clinics, including our latest in Chicago, IL.



